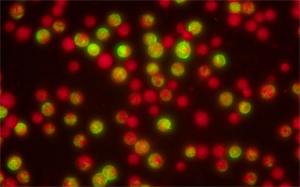
免疫熒光顯微鏡檢測呼吸道九聯(lián)檢.jpg

呼吸道九聯(lián)檢一般采用間接免疫熒光法,通過熒光素標(biāo)記的抗人球蛋白與抗原抗體復(fù)合物反應(yīng),用免疫熒光顯微鏡觀察結(jié)果。
免疫熒光顯微鏡檢測呼吸道九聯(lián)檢要用幾組熒光?
在呼吸道九聯(lián)檢的熒光檢測中,熒光信號的激發(fā)與識別依賴特定波長的光波段,核心圍繞“激發(fā)光(讓熒光素發(fā)光的光)”和“發(fā)射光(熒光素實(shí)際發(fā)出的光)”兩個關(guān)鍵環(huán)節(jié),具體波段選擇與檢測中使用的熒光素種類直接綁定(臨床最常用的是異硫氰酸熒光素FITC)。

正置三色熒光模塊匹配奧林巴斯BX53顯微鏡應(yīng)用于廣州某三甲醫(yī)院呼吸道病毒檢測
用藍(lán)光激發(fā)FITC熒光素→熒光素釋放綠光(陽性信號),同時背景染料釋放紅光→顯微鏡通過濾片組篩選出這兩種光,最終呈現(xiàn)“綠信號(病原體陽性)+紅背景(陰性區(qū)域)”的清晰視野,波段無重疊,不會干擾陽性信號的識別,醫(yī)生能通過“紅光背景中的綠光斑點(diǎn)”快速定位陽性區(qū)域。
激發(fā)光 465-495nm(藍(lán)光) 熒光素(FITC)需要吸收特定能量的光才能“被激活”,465-495nm的藍(lán)光恰好能提供其所需能量,促使FITC的電子從“基態(tài)”躍遷到“激發(fā)態(tài)”。
發(fā)射光 515-535nm(綠光) 激發(fā)態(tài)的電子不穩(wěn)定,會快速回到基態(tài)并釋放能量,能量以“光”的形式釋放,即發(fā)出515-535nm的綠光,這也是顯微鏡下觀察到的“陽性信號色”。
背景染料的波段:紅色信號用于定位與對比
為了避免“熒光信號淹沒在背景中”,試劑盒會添加紅色背景染料(如碘化丙啶PI、EvansBlue),其作用是給“非目標(biāo)區(qū)域”(如細(xì)胞、載玻片背景)染色,形成“綠信號(陽性)+紅背景(陰性)”的清晰對比。
很多用戶選擇在已有的生物顯微鏡升級改造為熒光顯微鏡,利用LED熒光模塊將普通生物顯微鏡改造為適用于呼吸道九聯(lián)檢的熒光顯微鏡,是臨床檢測中低成本、高效的方案。選擇升級LED熒光模塊,主要是因?yàn)槠渚哂袩晒庑Ч谩⒉僮骱啽?、使用壽命長、成本效益高等優(yōu)勢,能夠有效提升醫(yī)院的檢測水平和工作效率。

廣州明慧提供LED熒光模塊升級熒光顯微鏡,替代傳統(tǒng)激發(fā)光源,具備穩(wěn)定、低發(fā)熱、壽命長的優(yōu)勢,傳統(tǒng)汞燈需預(yù)熱且壽命短,LED更適合臨床高頻使用,該方案成本僅為專業(yè)熒光顯微鏡的1/5-1/3,且操作便捷、維護(hù)成本低,特別適合醫(yī)院或應(yīng)急檢測場景的快速部署免疫熒光顯微鏡檢測呼吸道九聯(lián)檢。

熱線020-87096762

致電13418179239

